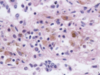

Artefakter Flashcards
Vad för artefakt?

“Mjäll”
Vad är det för artefakttyp och vad beror det på?

Sprickor, beror på överdehydrering
Vilka två artefakter finns här?

Värmeskador och förkalkningar
Vad är detta för typ av artefakt och vad markerar den gula ringen?

Frysskador
Gul ring markerar iskristaller i vävnaden
Vad är detta?

Melaninpigment
Vilken artefakt?

Paraffin av frys
Vilken artefakt?

Frysskada
Vad är det för artefakt?

Formalinpigment
Artefakter orsakade av själva provtagningen?
- Klämskador
- Trasiga preparat
- Värmeskador
- Dålig representativitet
- Otillräckligt med material
Typ av artefakt?

Förkalkning
Vilka artefakter finns här?

Veck, sprickor och bubbla i klistret
Vad är det för artefakt?

Paraffinkasset-frimärke, alltså har vävnadsbiten varit för stor/tjock för kassetten och den har klämts
Vilka huvudtyper av artefakter finns det?
Orsakade vid själva provtagningen, fixeringsrelaterade, dehydreringsfel, färgningsfel, tekniska och “hantverksrelaterade”
Vad är detta?
Hemosideringpigment
Vad är det för artefakt?

Microshatter, kan bero på torrt preparat (överdehydrering), värmeskada eller knivskada
Vad beror artefakten på?

Tuschning
Typ av artefakt?

Knivkontamination
Vilken artefakt?

Paraffin av frys
Vad är det för artefakttyp och vad beror det på?

Sprickor, beror på överdehydrering av preparat
Vilken artefakttyp?

Veck i snittet
Fixeringsrelaterade artefakter?
- Felaktigt fixativ
- För kort fixeringstid
- Otillräcklig fixering - för lite medel i förhållande till preparat, dålig penetration, ej genomskurna kapslade organ
Vad är det för artefakt?

Värmeskador
Vad är felet här?

Otillräcklig mängd vävnad är nedsnittad, så alla viktiga strukturer syns inte ännu
Tekniska eller hantverksrelaterade artefakter?
- Orientering vid nedläggning eller bäddning
- Utskärnings-“samplings”-relaterade
- Snittkvalitet
- Placering av snitt
- Montering
- Sammanblandningar
- Kontamination vid utskärning eller snittning
Vad är det för artefakt?

Värmeskador
Vad beror artefakten på?

Omild provtagning
Vad är detta?

Skräp under täckglaset
Vad är det för artefakt?

Formalinpigment